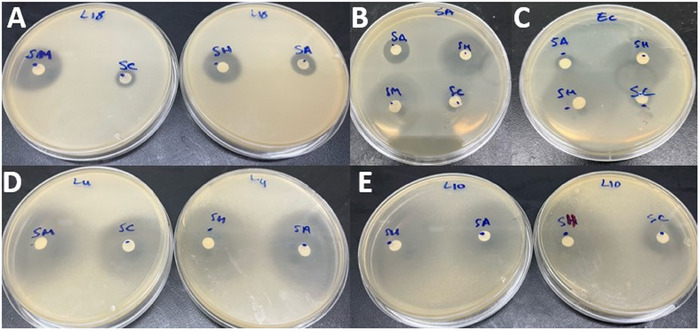
PMC12270359 – cbdv202402093-fig-0003

Chemical Composition and Synergistic Antimicrobial Effects of Essential Oils From Four Commonly Used Satureja Species in Combination With Two Conventional Antibiotics
Abstract
The chemical composition and the antimicrobial potency of four Satureja essential oils (EOs), and their synergism with two antimicrobials have been investigated. Gas chromatography (GC) and GC/mass spectrometry analysis showed that S. alpina EO was predominated by pulegone (88.8%), while pulegone (38.6%) and menthone (30%) were the major constituents of S. calamintha EO. S. montana and S. hortensis EOs were dominated by carvacrol (50.8%–32.8%), γ‐terpinene (18.5%–40.1%), and p‐cymene (8.2%–7.3%), respectively. The antimicrobial activity showed that S. montana and S. hortensis EOs exhibited potent activity (minimal inhibitory concentration and minimum microbiocidal [bactericidal and candidacidal] concentrations = 0.07–4.46 mg/mL for bacteria, and 0.27–1.11 mg/mL for Candida). All EOs showed high synergism with gentamicin against bacteria (gains ranged between 4‐ and 512‐fold). Interestingly, this synergism was pronounced against the Gram‐negative bacteria Escherichia coli and Pseudomonas aeruginosa. Regarding the association with amphotericin B, synergistic and additive effects were recorded depending on the strain tested.
Article type: Research Article
Keywords: antibiotics, antimicrobial activity, essential oils, synergism
Affiliations: Laboratory of Water Sciences, Microbial Biotechnologies, and Natural Resources Sustainability (AQUABIOTECH), Unit of Microbial Biotechnologies, Agrosciences, and Environment (BIOMAGE)‐CNRST Labeled Research Unit No. 4, Faculty of Sciences‐Semlalia University Cadi Ayyad Marrakech Morocco; Department of Biomedical, Surgical and Dental Sciences Università degli Studi di Milano Milan Italy; National Interuniversity Consortium of Materials Science and Technology Florence Italy
License: © 2025 The Author(s). Chemistry & Biodiversity published by Wiley‐VHCA AG. CC BY 4.0 This is an open access article under the terms of the http://creativecommons.org/licenses/by/4.0/ License, which permits use, distribution and reproduction in any medium, provided the original work is properly cited.
Article links: DOI: 10.1002/cbdv.202402093 | PubMed: 40014760 | PMC: PMC12270359
Relevance: Moderate: mentioned 3+ times in text
Full text: PDF (1.3 MB)
Introduction
Antimicrobial resistance (AMR) has been described as a major risk in healthcare systems and is emerging as a problem in community‐acquired infections [ref. 1, ref. 2]. AMR has been ranked by the World Health Organization (WHO) among the top 10 global public health hazards facing mankind in which conventional antimicrobials turn out to be ineffective in the treatment of infections for which they were specially conceived [ref. 3]. Many previous reports highlighted the negative economic and clinical impacts of AMR. In fact, it has been estimated that annually 700 000 persons die worldwide due to infections caused by multi‐drug resistant bacteria, and there is no doubt that this number will increase in the coming years [ref. 4, ref. 5]. In 2019, the United Nations Interagency Coordination Group on AMR alerted that, in the absence of efficient strategies, antibiotic‐resistant diseases could cause annually 10 million deaths by 2050, with a projected cost to be around 100 trillion dollars, and could force up to 24 million people into extreme poverty [ref. 6]. Faced with this alarming situation, the development of novel antimicrobial agents to control AMR seemed to be an urgent global need. Recently, in the absence of new effective drugs and to counteract this AMR, many studies and reviews have highlighted the potential application of some plant‐based extracts (e.g., essential oils [EOs]) as promising alternative biobased antimicrobials [ref. 7, ref. 8, ref. 9]. In fact, several reports pointed out the interesting antimicrobial properties of some plant EOs against a broad spectrum of pathogenic microorganisms, mainly due to their lipophilicity and their phytochemical diversity [ref. 10]. These characteristics led to EO components easily passing through the phospholipid bilayer of the bacterial cell membrane and interacting with different cellular constituents, affecting several metabolic and physiological processes that are crucial for cell survival [ref. 11, ref. 12]. In addition to their simultaneously multiple target sites in microbial cells, EOs as a source of bioactive ingredients, have the cumulative advantage of being biodegradable, cost‐effective, eco‐friendly, and with no adverse side effects [ref. 12, ref. 13]. Regarding these properties and in order to tackle the development of resistance, many studies have investigated the possible synergism between effective EOs and antibiotics [ref. 14, ref. 15, ref. 16]. This approach has proven effective in overcoming bacterial resistance mechanisms, thereby increasing the susceptibility of pathogens to antibiotics. In fact, many studies have shown that certain components of EOs can inhibit bacterial efflux pumps, which are typically responsible for expelling antibiotics from cells, thereby potentially enhancing the drug’s effectiveness [ref. 7, ref. 9, ref. 10]. Additionally, because EOs can target multiple cellular sites, they can produce a more pronounced overall impact [ref. 17]. Thus, this combination antibiotic therapy has been suggested as a promising and powerful strategy to restore the efficacy of some conventional antimicrobials to resistant pathogenic microorganisms [ref. 16].
The genus Satureja (Lamiaceae) includes various aromatic and medicinal species that are largely used as valuable ingredients for food, cosmetics, and pharmaceutical industries [ref. 18]. Of these Satureja species, S. hortensis, S. montana, S. alpina, and S. calamintha are of great economic importance due to their richness in EOs, which are traditionally exploited in Mediterranean regions to treat various infectious illnesses. Several previous works have highlighted the interesting antimicrobial properties of some Satureja EOs, including the winter savory EO (S. montana) [ref. 19, ref. 20]. However, little information is available on the antimicrobial potency of other commonly used Satureja species and their potential synergism with antibiotics. Thus, the present works aimed to compare the antimicrobial activity of EOs obtained from these four Satureja species and to investigate their potential synergistic combinations with two well‐known antibiotics (gentamicin and amphotericin B) against a panel of pathogenic bacteria and candida.
Results and Discussion
EO Yields and Chemical Composition
The EOs obtained from aerial parts of studied Satureja species through hydro‐distillation were observed to be of pale‐yellow color, with variable yields ranging from 0.42 ± 0.03% to 2.14 ± 0.12 % (w/w) based on dry weight (Table 1). The highest oil yield was observed in S. montana, while S. alpina yielded the lower value (Table 1). The results of the chemical analysis of the volatile constituents of Satureja EOs with the percentage content of each compound and structural subclass are presented in Figure 1 and Table 2. Twenty‐six compounds were identified, accounting for 96.2%–98.76% of the total EO constituents. The studied Satureja EOs were quantitatively dominated by the oxygenated monoterpenes class (56.6%–93.5%), except S. hortensis EO which was dominated by the group of monoterpene hydrocarbons (57.3%), then oxygenated monoterpenes (34.6%). GC and GC/MS analysis revealed a high content of the monoterpene pulegone (88.2%) in S. alpina EO, while pulegone (38.6%), menthone (30%) and menthol (21.2%) were identified as major constituents of S. calamintha EO, which is consistent with previous studies conducted on specimens originating from the Moroccan origin [ref. 21, ref. 22]. Nonetheless, other EO profiles characterized by high levels of 1,8‐cineole, β‐phellandrene, and pinocamphone have been documented for this species obtained from northern Morocco [ref. 23]. Concerning S. alpina EO, a high content of monoterpene pulegone has been identified, aligning with chemical profiles observed in EOs from other Moroccan samples [ref. 24, ref. 25]. The EOs of S. montana and S. hortensis were dominated essentially by the phenolic monoterpene carvacrol (50.8% and 32.8%) followed by γ‐terpinene (18.5% and 40.1%) and p‐cymene (8.2% and 7.3%), respectively. These findings align closely with previously reported profiles for these aromatic species [ref. 19, ref. 20, ref. 26, ref. 27]. However, in some studies [ref. 28, ref. 29, ref. 30], thymol has been consistently identified either along with these three components or as the primary constituent in EOs obtained from different other samples. It’s noteworthy that both thymol and carvacrol have been established as distinctive components within the species’ chemotypes, indicating substantial chemical polymorphism within these species [ref. 31, ref. 32, ref. 33].
TABLE 1: Locality, harvesting location and period, voucher specimens, and EO yield of the four Satureja species studied.
| Species | Local name | Harvesting place | Harvesting time | Voucher specimens | Latitude/Longitude | Oil yieldcbdv202402093-tbl1-note-0001 (mg / 100 g) |
|---|---|---|---|---|---|---|
| S. calamintha | Minta | Oukaimeden | July 2022 | SATCA019 | 31°11′N/07°53′W | 1.53 ± 0.13 |
| S. alpina | Fliou dial lbar | Oukaimeden | July 2022 | SATAL057 | 31°13′N/07°53′W | 0.42 ± 0.03 |
| S. montana | Zaater erroumi | Oulad Dlim | September 2022 | SATMO017 | 32°01’N/08°13’W | 2.14 ± 0.12 |
| S. hortensis | Zaater erroumi | Oulad Dlim | September 2022 | SATHO012 | 32°01’N/08°14’W | 1.25 ± 0.04 |
yield of EOs determined based on their weight / 100 g of dried plant used for distillation.

TABLE 2: Chemical compositions of studied Satureja EOs.
| RTcbdv202402093-tbl2-note-0001 | RIcbdv202402093-tbl2-note-0002 | RIcbdv202402093-tbl2-note-0003 | Compounds | S. montana | S. hortensis | S. calamintha | S. alpina |
|---|---|---|---|---|---|---|---|
| 2.67 | 968 | 924 | β‐Thujene | 1.3 | 1.7 | — | 0.4 |
| 2.76 | 973 | 932 | α‐Pinene | —cbdv202402093-tbl2-note-0004 | 1.1 | 0.5 | 0.1 |
| 3.01 | 980 | 969 | Sabinene | 1.2 | — | 0.1 | 0.2 |
| 3.15 | 981 | 990 | α‐Myrcene | 2.2 | 2.6 | 0.1 | 0.7 |
| 3.51 | 1010 | 1014 | α‐Terpinene | 3.1 | 4.5 | 0.7 | — |
| 3.60 | 1016 | 1020 | p‐Cymene | 8.2 | 7.3 | — | — |
| 3.61 | 1031 | 1024 | D‐Limonene | — | — | 1.6 | 3.9 |
| 3.72 | 1035 | 1026 | 1,8‐Cineole | — | 1.2 | 1.6 | — |
| 4.02 | 1047 | 1054 | γ‐Terpinene | 18.5 | 40.1 | — | 0.1 |
| 4.15 | 1056 | 1098 | trans‐Sabinene hydrate | 1.1 | — | — | — |
| 4.91 | 1101 | 1112 | trans‐Thujone | 1.6 | 0.7 | — | — |
| 5.41 | 1136 | 1148 | Menthone | — | — | 30.0 | 0.8 |
| 5.59 | 1155 | 1167 | Menthol | — | — | 21.2 | 0.3 |
| 5.80 | 1160 | — | trans‐Menthone | — | — | 1.0 | 1.6 |
| 5.84 | 1162 | 1165 | Borneol | 1.1 | — | — | — |
| 6.03 | 1164 | 1174 | Terpinen‐4‐ol | 1.0 | — | — | 0.3 |
| 6.08 | 1182 | 1179 | Isomenthol | — | — | 0.1 | 0.9 |
| 7.13 | 1237 | 1233 | Pulegone | — | — | 38.6 | 88.2 |
| 7.43 | 1240 | 1316 | Citral | 1.0 | — | 0.4 | 0.1 |
| 8.4 | 1298 | 1298 | Carvacrol | 50.8 | 32.8 | — | — |
| 8.70 | 1335 | 1340 | Piperitone | — | — | 0.6 | 0.4 |
| 11.96 | 1419 | 1417 | Caryophyllene | 2.7 | 2.1 | 2.0 | 0.6 |
| 13.59 | 1477 | 1478 | γ‐Muurolene | 1.6 | — | — | — |
| 14.01 | 1494 | 1484 | Germacrene D | 0.9 | — | — | — |
| 14.22 | 1531 | 1506 | α‐Bisabolene | 2.2 | 2.2 | — | — |
| 15.98 | 1601 | 1582 | Caryophyllene oxide | — | — | 0.3 | 0.1 |
| Oxygen‐containing monoterpenes | 56.6 | 34.6 | 93.5 | 92.6 | |||
| Monoterpene hydrocarbons | 34.5 | 57.3 | 3.0 | 5.4 | |||
| Oxygen‐containing sesquiterpenes | — | — | 0.3 | 0.1 | |||
| Sesquiterpene hydrocarbons | 7.4 | 4.3 | 2.0 | 0.6 | |||
| Total | 98.5 | 96.2 | 98.8 | 98.7 | |||
RT: retention time.
RI: Retention index relative to n‐alkanes (C7‐C30) on the TG‐5MS capillary column.
RI: Retention indices from literature (Adams, 2007).
not detected.
The values in bold are the dominant compounds.
Antimicrobial Activity of Satureja EOs
The zones of microbial growth inhibition were measured in order to assess the initial antimicrobial screening of studied Satureja EOs. The findings showed variable inhibition zone (IZ) diameter values, ranging from 6.18 ± 0.14 to 37.14 ± 0.13 mm for the tested bacteria and from 10.69 ± 0.21 to 42.16 ± 0.24 mm for the tested Candida strains (Figure 2). The EOs extracted from S. montana and S. hortensis showed the most significant inhibitory effect against all the tested strains, with IZ values reaching up to 42.16 ± 0.24 mm (Figure 3). These values were generally greater than those produced by the reference antimicrobials gentamicin and amphotericin B. In terms of the minimal inhibitory concentration (MIC) and minimum microbiocidal (bactericidal and candidacidal) concentrations (MMC) results, the findings align closely with the observed IZs, thereby reaffirming the previously reported antimicrobial effectiveness of these two aromatic plants [ref. 19, ref. 20, ref. 23, ref. 25, ref. 27]. Comparatively, the EO extracted from S. montana exhibited the highest potency, with MIC = MMC values within the range of 0.07–1.14 mg/mL, followed by the S. hortensis EO values, demonstrating notable efficacy with MICs and MMCs ranging from 0.28 to 4.46 mg/mL (Table 3). The EO from S. montana distinguished itself among the four oils investigated due to its interesting bactericidal activity at a low concentration (MIC = MMC = 0.57 mg/mL) against the Gram‐negative Pseudomonas aeruginosa. This strain demonstrated greater resistance to other Satureja EOs, especially S. calamintha and S. alpina. However, this activity was lower than that of the antibiotic gentamicin. The interesting activity observed in S. montana and S. hortensis EOs can primarily be attributed to the abundance of highly bioactive antimicrobial compounds, particularly carvacrol, γ‐terpinene, and p‐cymene, prevalent in these two EOs [ref. 34]. Indeed, the antimicrobial effectiveness of these monoterpenoids has been demonstrated in many previous reports, with the phenolic compound carvacrol notably displaying higher activity in comparison to other monoterpenoids [ref. 31, ref. 32, ref. 33]. This can explain the comparatively higher activity observed in the EO from S. montana, given its elevated proportion of carvacrol compared to that found in S. hortensis. Indeed, the hydroxyl group, a distinctive element in the phenolic structure of carvacrol, plays a crucial role in enhancing its effectiveness. The antimicrobial action of carvacrol has been extensively documented, including its capability to disrupt microbial cell membranes. Specifically, carvacrol interferes with the lipid bilayer, inducing structural alterations that heighten permeability and ultimately result in cell lysis. Furthermore, it has been noted to impede ATPase activity, essential for cellular energy production, thereby augmenting the inhibition of microbial growth [ref. 32, ref. 35, ref. 36]. Regarding the antimicrobial activity of S. calamintha and S. alpina EOs, less pronounced effects have been observed, with IZ diameters ranging from 6.18 ± 0.14 to 21.81 ± 0.80 mm indicating less to moderate activity. Concerning the MIC values, the S. calamintha and S. alpina EOs displayed relatively promising effects against Candida strains (MIC range: 2.23–4.47 mg/mL), while their activity against tested bacteria appeared comparatively weaker. This result is consistent with earlier reported results [ref. 37, ref. 38, ref. 39]. The reduced antimicrobial activity observed in these EOs could be linked to their abundance in pulegone, a monoterpene ketone known for its lower effectiveness when compared to phenolic monoterpenes [ref. 40]. Overall, the MMC values for all the studied EOs either equaled or showed minimal variation compared to their MICs, confirming their substantial microbicidal effectiveness.

TABLE 3: Minimal inhibition concentration (MIC) and minimal microbicidal concentration (MMC) of tested EOs and antibiotics against six panel of bacterial and four candida strains.
| Essential oils | Antibiotics | |||||||||
|---|---|---|---|---|---|---|---|---|---|---|
| Microorganismes | S. alpina | S. hortensis | S. montana | S. calamintha | Gentamicin | Amphotericin B | ||||
| MIC | MMC | MIC | MMC | MIC | MMC | MIC | MMC | MIC | MIC | |
| S. aureus | 36.68 | 36.68 | 1.12 | 2.23 | 0.29 | 0.29 | 35.80 | >35.8 | 0.312 | — |
| M. luteus | 18.34 | 18.34 | 0.28 | 0.28 | 0.07 | 0.07 | 17.90 | 17.90 | 0.625 | — |
| B. subtilis | 18.34 | 36.68 | 0.28 | 0.28 | 0.07 | 0.07 | 17.90 | 17.90 | 0.312 | — |
| E. coli | 18.34 | 18.34 | 1.12 | 1.12 | 1.14 | 1.14 | 17.90 | 17.90 | 5.00 | — |
| P. aeruginosa | >36.68 | >36.68 | 4.46 | 4.46 | 0.57 | 0.57 | >35.8 | >35.8 | 5.00 | — |
| K. pneumoniae | 18.34 | 18.34 | 0.56 | 0.56 | 0.57 | 0.57 | 17.90 | 17.90 | 160 | — |
| C. albicans L4 | 2.29 | 9.17 | 0.28 | 0.28 | 0.57 | 0.57 | 2.23 | 2.23 | —cbdv202402093-tbl3-note-0001 | 3.125 |
| C. glabrata L7 | 2.29 | 4.58 | 0.55 | 0.55 | 0.57 | 0.57 | 2.23 | 4.47 | — | 1.56 |
| C. krusei L10 | 2.29 | 9.17 | 1.11 | 1.11 | 0.28 | 0.28 | 4.47 | 8.95 | — | 0.78 |
| C. parapsilosis L18 | 2.29 | 2.29 | 1.11 | 1.11 | 0.57 | 0.57 | 4.47 | 4.47 | — | 1.56 |
MIC and MMC are in mg/mL for EOs and in µg/mL for antibiotics; aNot tested.
Synergistic Effect of Satureja EOs With Conventional Antimicrobials
The results detailing the synergistic interactions, including MIC gain and fractional inhibitory concentration index (FICI) values of antibiotics, observed between the studied Satureja EOs and conventional antimicrobials amphotericin B and gentamicin are given in Tables 4 and 5, respectively. The combinations between Satureja EOs and the antifungal amphotericin B exhibited different types of interactions depending on the tested Candida strains. Of the combinations tested, those prepared with S. alpina and S. montana EOs demonstrated synergistic effects against Candida albicans and C. glabrata, with FICI values ranging between 0.375 and 0.5. These combinations notably reduced the antifungal MICs by 4‐ to 8‐fold. S. calamintha EO showed synergistic interaction against C. albicans, C. glabrata, and C. krusei (FICI = 0.5 and MIC gain = 4), and additive effect against C. parapsilosis, while S. hortensis showed synergistic interaction against C. glabrata, additivity against C. albicans and C. krusei, and indifference against C. parapsilosis. Regarding bacterial strains, the combinations of the investigated EOs and gentamicin generated more pronounced synergistic effects across all tested bacterial strains, with FICI values ranging between 0.252 and 0.5 (Table 5). Remarkably, all combinations tested displayed heightened synergistic effects against both the Gram‐negative Escherichia coli and P. aeruginosa, with an FICI of 0.25 and a significant reduction in antibiotic MICs by up to 512‐fold. These findings are in agreement with those reported by Vitanza et al. [ref. 20]., which showed that S. montana interacts synergistically with the antibiotic gentamicin against reference and clinical bacterial strains of E. coli, S. aureus, and Listeria monocytogenes. As far as we know, except for this study, the synergistic combinations of studied Satureja EOs with antimicrobial drugs have not been explored in previous research. Nevertheless, it is worth noting that the EOs under investigation are distinguished by the presence of key compounds known for their potent antimicrobial synergistic interactions with various antimicrobial agents. For instance, carvacrol, which is the predominant compound of studied S. montana and S. hortensis EOs, has been reported to possess high synergism with many conventional antibiotics, including amphotericin B and gentamicin [ref. 14, ref. 15, ref. 41].
TABLE 4: Fractional inhibitory concentration index (FICI) and MIC gain of amphotericin B (amph) combined with EOs obtained from studied Satureja species.
| Essential oils | Strains | MIC amph (µg/mL) | MIC amph + EO | FIC (amph) | FIC (EO) | FICI | Gain |
|---|---|---|---|---|---|---|---|
| S. alpina | C. albicans | 3.125 | 0.39 | 0.125 | 0.25 | 0.375 | 8 |
| C. glabrata | 1.56 | 0.39 | 0.25 | 0.25 | 0.5 | 4 | |
| C. krusei | 0.78 | 0.39 | 0.5 | 0.25 | 0.75 | 2 | |
| C. parapsilosis | 1.56 | 0.78 | 0.5 | 0.25 | 0.75 | 2 | |
| S. calamintha | C. albicans | 3.125 | 0.78 | 0.25 | 0.25 | 0.5 | 4 |
| C. glabrata | 1.56 | 0.39 | 0.25 | 0.25 | 0.5 | 4 | |
| C. krusei | 0.78 | 0.195 | 0.25 | 0.25 | 0.5 | 4 | |
| C. parapsilosis | 1.56 | 0.78 | 0.5 | 0.25 | 0.75 | 2 | |
| S. montana | C. albicans | 3.125 | 0.78 | 0.25 | 0.25 | 0.5 | 4 |
| C. glabrata | 1.56 | 0.39 | 0.25 | 0.25 | 0.5 | 4 | |
| C. krusei | 0.78 | 0.78 | 1 | 0.25 | 1.25 | 1 | |
| C. parapsilosis | 1.56 | 1.56 | 1 | 0.25 | 1.25 | 1 | |
| S. hortensis | C. albicans | 3.125 | 1.562 | 0.5 | 0.25 | 0.75 | 2 |
| C. glabrata | 1.56 | 0.39 | 0.25 | 0.25 | 0.5 | 4 | |
| C. krusei | 0.78 | 0.39 | 0.5 | 0.25 | 0.75 | 2 | |
| C. parapsilosis | 1.56 | 1.56 | 1 | 0.25 | 1.25 | 1 |
TABLE 5: Fractional inhibitory concentration index (FICI) and MIC gain of gentamicin (gent) and EOs obtained from studied Satureja species.
| Essential oils | Bacteria | MIC Gent (µg/mL) | MICgent + EO | FIC (gent) | FIC (EO) | FICI | Gain |
|---|---|---|---|---|---|---|---|
| S. alpina | S. aureus | 0.312 | 0.002 | 0.007 | 0.25 | 0.257 | 128 |
| M. luteus | 0.625 | 0.004 | 0.0625 | 0.25 | 0.3125 | 16 | |
| B. subtilis | 0.31 | 0.002 | 0.007 | 0.25 | 0.257 | 128 | |
| E. coli | 5 | 0.019 | 0.004 | 0.25 | 0.254 | 256 | |
| P. aeruginosa | 5 | 0.019 | 0.004 | 0.25 | 0.254 | 256 | |
| K. pneumoniae | 160 | 26.66 | 0.166 | 0.25 | 0.416 | 16 | |
| S. calamintha | S. aureus | 0.312 | 0.078 | 0.25 | 0.25 | 0.5 | 4 |
| M. luteus | 0.625 | 0.078 | 0.125 | 0.25 | 0.375 | 8 | |
| B. subtilis | 0.31 | 0.0006 | 0.002 | 0.25 | 0.252 | 512 | |
| E. coli | 5 | 0.019 | 0.004 | 0.25 | 0.254 | 256 | |
| P. aeruginosa | 5 | 0.019 | 0.004 | 0.25 | 0.254 | 256 | |
| K. pneumoniae | 160 | 5 | 0.031 | 0.25 | 0.281 | 32 | |
| S. montana | S. aureus | 0.312 | 0.001 | 0.004 | 0.25 | 0.254 | 256 |
| M. luteus | 0.625 | 0.156 | 0.25 | 0.25 | 0.5 | 4 | |
| B. subtilis | 0.31 | 0.004 | 0.015 | 0.25 | 0.265 | 64 | |
| E. coli | 5 | 0.019 | 0.004 | 0.25 | 0.254 | 256 | |
| P. aeruginosa | 5 | 0.009 | 0.002 | 0.25 | 0.252 | 512 | |
| K. pneumoniae | 160 | 20 | 0.125 | 0.25 | 0.375 | 8 | |
| S. hortensis | S. aureus | 0.312 | 0.052 | 0.166 | 0.25 | 0.416 | 16 |
| M. luteus | 0.625 | 0.078 | 0.125 | 0.25 | 0.375 | 8 | |
| B. subtilis | 0.31 | 0.001 | 0.004 | 0.25 | 0.254 | 256 | |
| E. coli | 5 | 0.009 | 0.002 | 0.25 | 0.252 | 512 | |
| P. aeruginosa | 5 | 0.019 | 0.004 | 0.25 | 0.254 | 256 | |
| K. pneumoniae | 160 | 10 | 0.0625 | 0.25 | 0.3125 | 16 |
Conclusions
The results of the conducted research indicate that there is diversity in both the chemical composition and antimicrobial activity among the investigated Satureja EOs. S. montana and S. hortensis EOs, which contain high levels of phenolic monoterpene carvacrol, displayed strong antimicrobial effects against all tested strains. Conversely, EOs from S. calamintha and S. alpina, rich in monoterpene ketone pulegone, exhibited relatively weaker antimicrobial activity. Interestingly, all Satureja EOs demonstrated significant synergy with the antibiotic gentamicin, especially against some common pathogenic bacteria, such as Staphylococcus aureus, Bacillus subtilis, and the two Gram‐negative E. coli, and P. aeruginosa. This finding suggests that EOs from these Satureja species could serve as potential adjuvants to these conventional antibiotics, offering novel strategies for enhancing their antimicrobial efficacy. These insights hold promise for the pharmaceutical industry, contributing to drug development and promoting the integration of Satureja EOs as complementary antimicrobial agents.
Experimental
Plant Materials and EO Analysis
Aerial parts of S. alpina and S. calamintha were harvested from their natural populations situated in the Oukaimeden region, while S. montana and S. hortensis were collected from an experimental parcel located in Oulad Dlim in the Marrakech Region (Table 1). All the plant materials were harvested during the full flowering period in the year 2022. The botanical identification of the plant material was confirmed by Pr. Mohamed Taleb Sghir, and voucher specimens (SATAL057, SATCA019, SATMO017, and SATHO012 assigned to S. alpina, S. calamintha, S. montana, and S. hortensis, respectively) have been deposited at the Laboratory of Microbial Biotechnologies, Agrosciences, and Environment, University Cadi Ayyad. EO extractions were performed in triplicate (3 × 300 g of dried plant materials) using hydrodistillation with a Clevenger‐type apparatus. The aerial parts of the plants were first dried in the shade at room temperature (≈ 25°C) until a constant weight was reached. The dried plant materials were then immersed in distilled water and subjected to hydrodistillation for at least 3 hours, ensuring complete recovery of the EO. The extracted EOs were separated from the aqueous phase, and dried over anhydrous sodium sulfate. The triplicates of each extracted EO were combined into a single sample and stored in amber glass bottles at 4°C until further analysis. The extraction yields were calculated as % (v/w) based on the dry weight of plant materials.
The qualitative and quantitative identification of the EO constituents was conducted using gas chromatography (GC) and GC coupled to mass spectrometry (GC‐MS) as previously described by Soulaimani et al. [ref. 42]. To identify the individual compounds of the chromatographic profile for each oil on a single analysis, the mass spectra were compared to authentic reference compounds where possible, and by reference to NBS75K and WILEY275 libraries, and a published terpene library [ref. 43]. The retention indices (RIs) were calculated relative to the retention times of a series of C7–C30 n‐alkanes, with linear interpolation, and compared with those of authentic compounds or published data.
Determination of the Antimicrobial Activity
Microorganism Strains
Antimicrobial activity of the studied EOs was tested against four pathogenic clinically isolated Candida strains: C. albicans (CCMM L4), C. glabrata (CCMM L7), C. krusei (CCMM L10), and C. parapsilosis (CCMM L18), and six pathogenic bacteria: S. aureus (CCMMB3), Micrococcus luteus (ATCC 10,240), B. subtilis (ATCC 9524), E. coli (ATCC 8739), Klebsiella pneumoniae (Clinical isolate), and P. aeruginosa (DSM 50090).
Antimicrobial Screening
The antimicrobial activity of Satureja EOs was evaluated using the agar disc diffusion and microwell dilution methods as described in the Clinical and Laboratory Standards Institute guidelines [ref. 44, ref. 45]. For the agar diffusion test, sterile 6 mm diameter discs containing 10 µL of the EOs were applied to the surface of Sabouraud dextrose (SDA) or Mueller Hinton Agar (MHA) agar plates previously seeded by 0.1 mL of yeast or bacterial suspensions at 105 and 108 UFC/mL, respectively. All plates were kept at 4°C for 4 h to allow the EO diffusion before their incubation at 37°C for 24 h for bacteria, and at 28°C for 48 h for yeasts. Antimicrobial activities were evaluated by measuring the diameter of the IZs around the discs. All tests were repeated three times. Gentamicin (15 µg/disc) and amphotericin B (5 µg/disk) were used as positive controls. All assays were performed in triplicate. Regarding the microwell dilution method, 2‐fold serial dilutions of the EOs were prepared in 4% dimethyl sulfoxide and 100 µL of each dilution were added to microwells previously inoculated with 100 µL of yeasts or bacterial cell suspensions of 1–2 × 103 and 108 CFU/mL, respectively. The microplates were incubated for 18–24 h at 28°C for Candida strains and at 37°C for bacteria. The MIC was defined as the lowest EO concentration that inhibits the growth of the tested strains. To determine the MMC, 0.1 mL of clear wells that did not show growth during MIC assays were sub‐cultured on MHA or SDA depending on the strain type, and incubated in the same conditions described above. The MMC was defined as the lowest bactericidal and candidacidal EO concentrations. Gentamicin and amphotericin B were used as standard antibacterial and antifungal drugs, respectively.
Synergistic Effect of Satureja EOs With Antimicrobial Drugs
Synergistic effects of Satureja EOs with antimicrobial drugs (gentamicin and amphotericin B), were carried out using the checkerboard method [ref. 46]. Briefly, 50 µL of each antimicrobial dilution was mixed in a microwell with 50 µL of EO dilution, then inoculated by 100 µL of cell suspensions of 108 CFU/mL for bacteria and 1–2 × 103 CFU/mL for candida. The microplates were incubated in the appropriate conditions described above, and the results were expressed in terms of an FICI using the following formula:
with FIC of EO = MIC of EO in Combination/MIC of EO Alone
and
FIC of Antibiotic = MIC of Antibiotic in Combination/MIC of Antibiotic Alone
The FICI results were interpreted as: Synergism when FICI ≤ 0.5, additivity when 0.5< FICI ≤ 1, indifference when 1< FICI ≤ 2, or antagonism when FICI ≥ 2 [ref. 38].
The MIC gain of the antimicrobial drugs was calculated according to the following formula:
Author Contributions
Imane Abbad: writing–original draft preparation. Bouchra Soulaimani: writing–original draft preparation. Imane Abbad: methodology. Bouchra Soulaimani: methodology. Mustapha Barakate: methodology. Marcello Iriti: writing–review and editing. Mustapha Barakate: writing–review and editing. Marcello Iriti: conceptualization. Mustapha Barakate: conceptualization. All authors have read and agreed to the published version of the manuscript.
Conflicts of Interest
The authors declare no conflicts of interest.
References
- Antibiotic Stewardship Challenges in the Management of Community‐Acquired Infections for Prevention of Escalating Antibiotic Resistance,”. Journal of Global Antimicrobial Resistance, 2014. [PubMed]
- How Phages Overcome the Challenges of Drug Resistant Bacteria in Clinical Infections,”. Infection and Drug Resistance, 2020. [PubMed]
- 10 Global Health Issues to Track in 2021,. 2020
- 4 C. Barreiro and J. L. Barredo , “Worldwide Clinical Demand for Antibiotics: Is It a Real Countdown?” in Antimicrobial Therapies, Methods in Molecular Biology, eds. C. Barreiro and J. L. Barredo (Humana Press, 2021), 3–15.
- Antibiotic Resistance: The Challenges and Some Emerging Strategies for Tackling a Global Menace,”. Journal of Clinical Laboratory Analysis, 2022. [PubMed]
- Impact of Multi‐drug Resistant Bacteria on Economic and Clinical Outcomes of Healthcare‐associated Infections in Adults: Systematic Review and Meta‐analysis,”. PLoS One, 2020. [PubMed]
- A Comprehensive Review of the Antibacterial, Antifungal and Antiviral Potential of Essential Oils and Their Chemical Constituents Against Drug‐resistant Microbial Pathogens,”. Microbial Pathogenesis, 2019. [PubMed]
- Biological Activities of Essential Oils Extracted From Thymus capitatus (Lamiaceae),”. South African Journal of Botany, 2020
- Essential Oils and Its Antibacterial, Antifungal and Anti‐oxidant Activity Applications: A Review,”. Food Bioscience, 2022
- Antibacterial Plant Compounds, Extracts and Essential Oils: An Updated Review on Their Effects and Putative Mechanisms of Action,”. Phytomedicine, 2021. [PubMed]
- Antibacterial Mechanism of Oregano Essential Oil,”. Industrial Crops and Products, 2019
- Effectiveness and Mechanisms of Essential Oils for Biofilm Control On Food‐contact Surfaces: An Updated Review,”. Critical Reviews in Food Science and Nutrition, 2020
- Essential Oils and Their Nanoformulations as Green Preservatives to Boost Food Safety Against Mycotoxin Contamination of Food Commodities: A Review,”. Journal of the Science of Food and Agriculture, 2021. [PubMed]
- Synergy Between Essential Oil Components and Antibiotics: A Review,”. Critical Reviews in Microbiology, 2014. [PubMed]
- Combined Effect of Conventional Antimicrobials With Essential Oils and Their Main Components Against Resistant Streptococcus Suis Strains,”. Letters in Applied Microbiology, 2019. [PubMed]
- Synergistic Antioxidant and Antimicrobial Activities of Essential Oils of Some Selected Medicinal Plants in Combination and With Synthetic Compounds,”. Industrial Crops and Products, 2020
- The Role of Essential Oils in the Inhibition of Efflux Pumps and Reversion of Bacterial Resistance to Antimicrobials,”. Current Microbiology, 2021. [PubMed]
- A Pharmacological and Phytochemical Overview on Satureja,”. Pharmaceutical Biology, 2016. [PubMed]
- Evaluation of the Antimicrobial Effects of Satureja Montana Essential Oil Alone and in Combination With Nisin on Escherichia coli and Staphylococcus aureus ,”. Journal of Research in Medical and Dental Science, 2018
- Satureja Montana L. Essential Oil and Its Antimicrobial Activity Alone or in Combination with Gentamicin,”. Microbial Pathogenesis, 2019. [PubMed]
- Chemical Composition, Insecticidal and Allelopathic Properties of Essential Oils Obtained From Wild and Cultivated Moroccan Satureja Calamintha (L.),”. Journal of Natural Pesticide Research, 2023
- Acaricidal Properties of Essential Oils From Moroccan Plants Against Immature Ticks of Hyalomma Aegyptium (Linnaeus, 1758); An External Parasite of the Spur‐thighed Tortoise (Testudo graeca),”. International Journal of Acarology, 2018
- Chemical Composition, Antioxidant and Antimicrobial Properties of Mentha Pulegium, Lavandula Stoechas and Satureja Calamintha Scheele Essential Oils and an Evaluation of Their Bactericidal Effect in Combined Processes,”. Innovative Food Science and Emerging Technologies, 2014
- Chemical Composition and Antibacterial Screening of Aerial Parts of Essential Oils of Three Satureja Species (Satureja briquetti, Satureja atlantica and Satureja alpina) Growing Wild in the Middle Atlas Mountains of Morocco,”. Journal of Essential Oil Bearing Plants, 2018
- Optimization of the Insecticidal Response of Combined Essential Oils from Satureja Alpina, Rosmarinus officinalis and Ammodaucus Leucotrichus Using a Designed Mixtures Approach,”. International Journal of Tropical Insect Science, 2022
- The in Vitro Cytotoxicity, Antioxidant and Antibacterial Potential of Satureja Hortensis L. essential Oil Cultivated in Egypt,”. Bioorganic Chemistry, 2020. [PubMed]
- Composition and Biocidal Properties of Essential Oil From Pre‐domesticated Spanish Satureja montana ,”. Industrial Crops and Products, 2020
- Chemical Composition and Antifungal Activity of Satureja Hortensis L. Essential Oil against Planktonic and Biofilm Growth of Candida albicans Isolates From Buccal Lesions of HIV+ Individuals,”. Microbial Pathogenesis, 2016. [PubMed]
- Phytochemical Evaluation of Tinctures and Essential Oil Obtained From Satureja montana Herb,”. Molecules, 2020
- Antimicrobial and Antibiofilm Effects of Satureja Hortensis Essential Oil Against Escherichia coli and Salmonella Isolated From Poultry,”. Iran Journal of Microbiology, 2021
- Variation in Essential Oils to Study the Biodiversity in Satureja montana L.,”. Journal of Medicinal Plant Research, 2011
- Ecological Variation of Yield and Aroma Components of Summer Savory (Satureja hortensis L.),”. Journal of Applied Research on Medicinal and Aromatic Plants, 2017
- Morphological and Phytochemical Variability of Satureja Hortensis L. Accessions: An Effective Opportunity for Industrial Production,”. Industrial Crops and Products, 2021
- Synergistic Effects of Carvacrol, α‐terpinene, γ‐terpinene, ρ‐cymene and Linalool Against Gardnerella Species,”. Scientific Reports, 2022. [PubMed]
- Major Bioactivities and Mechanism of Action of Essential Oils and Their Components,”. Flavour and Fragrance Journal, 2013
- Synergistic Effect of Eugenol, Carvacrol, Thymol, p‐cymene and γ‐terpinene on Inhibition of Drug Resistance and Biofilm Formation of Oral Bacteria,”. Microbial Pathogenesis, 2017. [PubMed]
- Synergistic Effects of Carvacrol, α‐terpinene, γ‐terpinene, ρ‐cymene and Linalool Against Gardnerella Species,”. Scientific Reports, 2022. [PubMed]
- Terminology Relating to Methods for the Determination of Susceptibility of Bacteria to Antimicrobial Agents,”. Clinical Microbiology and Infection, 2000. [PubMed]
- The Phenolic Hydroxyl Group of Carvacrol Is Essential for Action Against the Food‐borne Pathogen Bacillus Cereus ,”. Applied and Environmental Microbiology, 2002. [PubMed]
- The Antibacterial Properties of Phenolic Isomers, Carvacrol and Thymol,”. Critical Reviews in Food Science and Nutrition, 2019. [PubMed]
- Composition Chimique Et Activité Antimicrobienne Des Huiles Essentielles De Satureja Calmintha Et Satureja Alpina Du Maroc,”. Annales des Falsifications, de l’Expertise Chimique & Toxicologique, 2001
- Arbuscular Mycorrhizal Fungi Associated With Endemic Moroccan Lavender (Lavandula maroccana Murb.): Effects On Plant Growth, Volatile Oil Composition and Antimicrobial Activity,”. Journal of Essential Oil Bearing Plants, 2023
- 43 R. P. Adams , Identification of Essential Oil Components by Gas Chromatography, 4th ed. (Allured Publishing Corp, 2007).
- 44 Clinical and Laboratory Standards Institute , Performance Standards for Antimicrobial Disk Susceptibility Tests, Approved Standard M02‐A12, 12th ed. (Clinical and Laboratory Standards Institute, 2015a).
- 45 Clinical and Laboratory Standards Institute , Methods for Dilution Antimicrobial Susceptibility Tests for Bacteria That Grow Aerobically, Approved Standard M07‐A10, 10th ed. (Clinical and Laboratory Standards Institute, 2015b).
- Novel Microdilution Method to Assess Double and Triple Antibiotic Combination Therapy In Vitro ,”. International Journal of Microbiology, 2016
